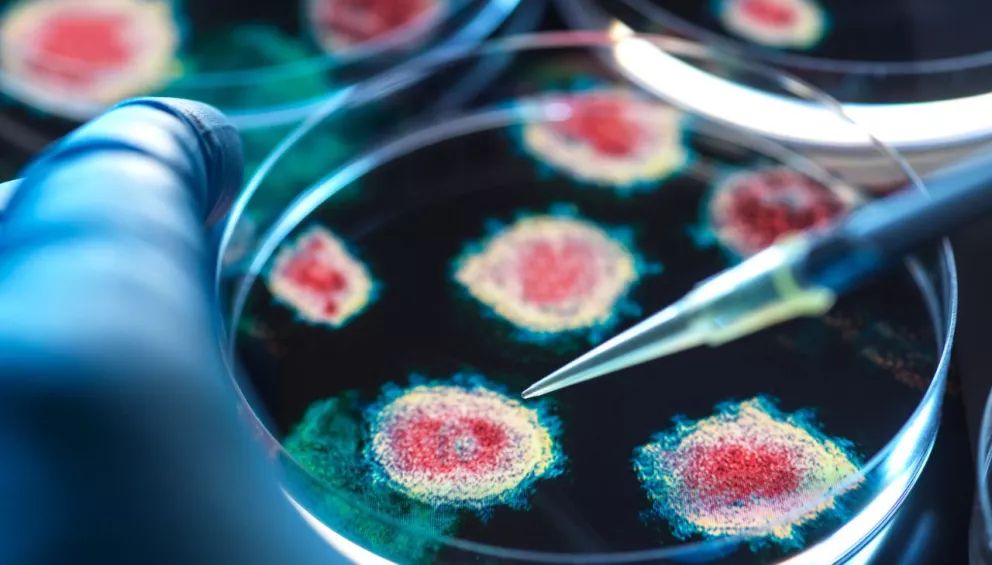
Virus nguy hiểm xuất hiện tại Mỹ: Người Việt có cần lo lắng?- Ảnh 1.

Virus nguy hiểm xuất hiện tại Mỹ: Người Việt có cần lo lắng?
- Thứ 5 , 06/02/2025, 12:36Mới đây, các chuyên gia Đại học Queensland công bố họ mới phát hiện ra virus Camp Hill, là chủng henipavirus đầu tiên xuất hiện ở Bắc Mỹ.
Virus Camp Hill được tìm thấy trong chuột chù ở Alabama, VnExpress đưa tin. Virus Camp Hill do các chuyên gia Đại học Queensland phát hiện hôm 4/2, là chủng henipavirus đầu tiên xuất hiện ở Bắc Mỹ.
Henipavirus có thể lây truyền từ động vật sang người. Theo tiến sĩ Rhys Parry, Trường Hóa học và Sinh học Phân tử, henipavirus đã gây bệnh nghiêm trọng và tử vong cho con người, động vật ở các khu vực khác.
Ví dụ, virus Langya - một chủng của henipavirus - lây từ chuột chù sang người tại Trung Quốc, gây các triệu chứng như sốt, mệt mỏi, ho, đau nhức cơ, rối loạn chức năng gan và tổn thương thận.
Một chủng khác là virus Hendra, phát hiện lần đầu tại Brisbane, Australia, với tỷ lệ tử vong lên đến 70%. Trong khi đó, virus Nipah, xuất hiện tại Đông Nam Á (Bangladesh và Ấn Độ), có tỷ lệ tử vong từ 40% đến 75%.
"Việc phát hiện henipavirus ở Bắc Mỹ rất quan trọng, cho thấy mầm bệnh có thể phân bố rộng hơn so với suy nghĩ trước đây, trên toàn cầu", tiến sĩ Parry nhấn mạnh.
Ảnh minh họa virus.
Người Việt Nam có cần lo lắng?
Liên quan tới sự việc này, PGS.TS Đỗ Văn Dũng, Trưởng khoa Y tế công cộng, nguyên phó hiệu trưởng Trường ĐH Y Dược TP.HCM, cho hay virus Camp Hill có thể lây từ động vật sang người. Các trường hợp nhiễm virus là do có tiếp xúc với động vật, đặc biệt là những người đi rừng, mua bán động vật hoang dã, đi vào các khu bảo tồn, làm việc chăm sóc động vật…
Trung tâm Kiểm soát và Phòng ngừa Dịch bệnh Mỹ (CDC) cũng cho biết nhóm có nguy cơ cao nhất nhiễm henipavirus là những người tiếp xúc trực tiếp với động vật nhiễm bệnh (chủ yếu là dơi và lợn) hoặc tiêu thụ thực phẩm bị nhiễm dịch cơ thể của các loài này. Nhân viên y tế điều trị bệnh nhân cũng thuộc nhóm nguy cơ cao.
Theo PGS Dũng, virus Camp Hill cho tới nay chưa ghi nhận tại Việt Nam, bệnh cũng không lây từ người sang người nên người dân không cần quá lo lắng.
Tuy nhiên, để phòng ngừa bệnh từ động vật hoang dã lây sang người, người dân không nên ăn uống – tiêu thụ, buôn bán các loại động vật hoang dã.
Theo số liệu của Tổ chức Quốc tế về Bảo tồn Thiên nhiên (WWF), năm 2022, Lào, Việt Nam và Campuchia là ba quốc gia sử dụng nhiều thịt động vật hoang dã. WWF cũng nhấn mạnh rằng việc sử dụng thịt thú rừng là nguyên nhân dẫn đến tình trạng buôn bán động vật hoang dã nhiều hơn, góp phần gây ra các thảm họa thiên nhiên, đe dọa nghiêm trọng tới cuộc sống toàn cầu.
Cũng theo khuyến cáo của Tổ chức Y tế thế giới (WHO), có nhiều minh chứng khoa học cho thấy khoảng 70% bệnh truyền nhiễm nguy hiểm mới nổi ở người có nguồn gốc từ động vật, trong đó có động vật hoang dã.
PGS Dũng cho hay hiện tại, chưa có phương pháp điều trị kháng virus đặc hiệu cho henipavirus. Việc điều trị chủ yếu tập trung vào chăm sóc hỗ trợ và quản lý các biến chứng.
